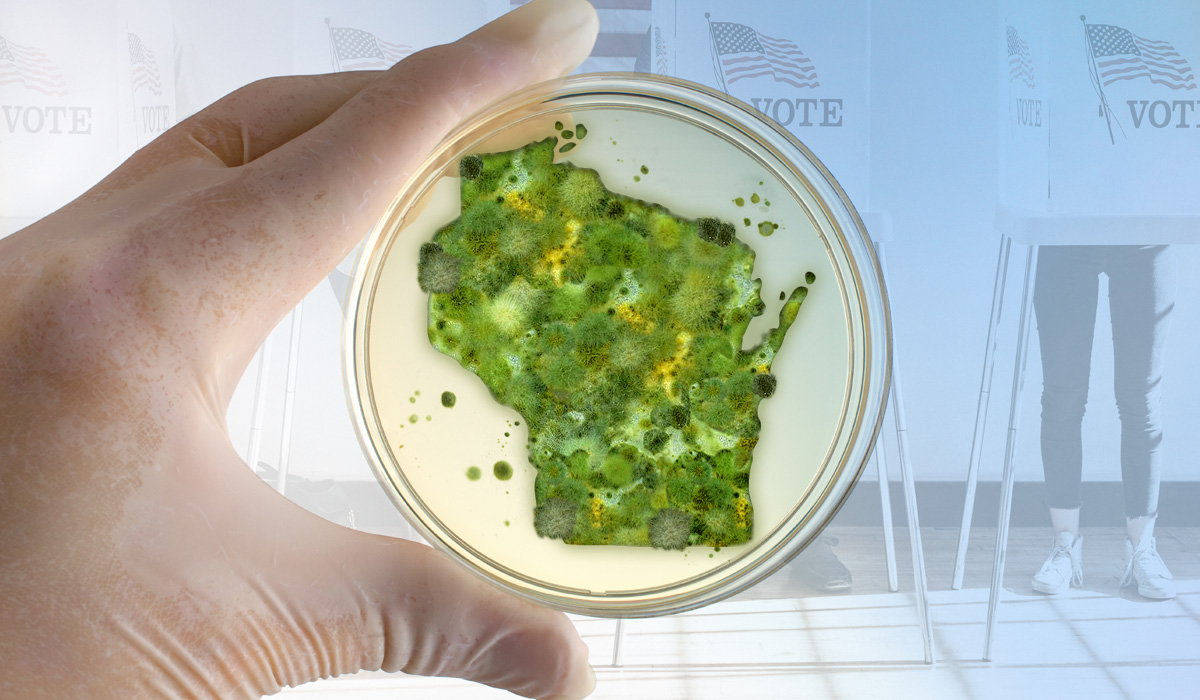

Local Elections Have National Consequences
The Left's Political Petri Dish
-by Joe Giganti
On March 11, 2011, then Gov. Scott Walker (R-Wis.) signed Act 10 into law. Act 10 successfully addressed an expected $3.6 billion budget deficit by reforming salary, benefits and, perhaps most importantly, the collective bargaining rights of public sector employees. Act 10 is rightly celebrated as having forever changed the political landscape of Wisconsin. But it had a surprising, somewhat detrimental, effect that is only now being recognized.
In the ensuing 12 years, Wisconsin has been transformed into a political petri dish by the Left whereby they undertake Frankensteinian political experiments, hell-bent on fundamentally transforming our state and federal government.
Two races in Wisconsin’s upcoming April election make these attempts crystal clear: the Green Bay mayor’s race and the State Supreme Court race. Writing off such races as “local politics that don’t affect me,” is a fatal mistake.
Green Bay Mayor Eric Genrich is seeking a second term on April 4. To fully understand the importance of this race, it is important to understand the history that has led up to it.
In April 2020, the rookie mayor wrecked the last Supreme Court election and presidential primary by reducing the normal 31 polling locations to just 2, under the guise of COVID safety. Those who actually got to vote waited in hours long lines in bad Wisconsin weather. Genrich steadfastly refused the assistance of the National Guard, which would likely have allowed all 31 sites to remain open.

By the general election that year, the corrupt mayor had literally given the keys to central count to a civilian from a Leftist non-governmental organization (NGO), granting him the power to oversee that year’s presidential vote count. In ensuing elections, Genrich has repeatedly been caught red-handed flaunting state statues, breaking the law (counting ballots outside the appointed time) and most recently spying on the citizenry with illegal listening devices.
Corruption unanswered metastasizes.
Unanswered corruption summarizes Genrich’s tenure in office. He continues to push the limits of legality and has the audacity to run for a second term despite his dismal record because he’s been allowed to get away with this corruption.
This is when the petri dish experiment could convert into a nationwide protocol. Genrich’s schemes have been funded largely by the left-wing Center for Tech & Civic Life (CTCL). All of his experiments have been designed to see how high he can push the corruption meter and get away with it. If he is re-elected, this will be deemed a success and this playbook will be franchised out to every small- and medium-size city not already under the stranglehold of woke, progressive policy.
The same is true of the Wisconsin Supreme Court race, but its impact could be even more disastrous.
According to a report by author Matt Palumbo, George Soros has spent $40 million to get 75 far-left prosecutors elected—representing approximately 20 percent of Americans. This list includes George Gascon (Los Angeles, Calif.), Kim Foxx (Cook Co., Ill.), Larry Krasner (Philadelphia, Penn.), and Alvin Bragg (Manhattan, NY) among others. Collectively, they have reclassified dozens of felonies to misdemeanors, refused to prosecute violent crime, and have transformed once-great cities into centers of chaos.
This has been a very successful experiment for the progressive left: fundamentally deconstructing the rule of law, the “civility” in civilization by packing district attorney offices with loyal foot soldiers.
Twenty-five states elect their state Supreme Court justices. Soros and his contemporaries see this as the next step in destroying an independent judiciary that provides the constitutionally mandated checks and balances to the legislative and executive branches of government.
In the Wisconsin matchup, it is former Wisconsin Supreme Court Justice Daniel Kelly, an accomplished constitutionalist, against self-proclaimed proud progressive Judge Janet Protasiewicz. By some accounts, as much as 96 percent of Protasiewicz’s donations are coming from out-of-state liberals and PACs, including some heavily funded by Soros.
Actress Julia Louis-Dreyfus is one of dozens of celebrities who have been lobbying Wisconsinites to vote for “No Jail Janet” as she’s been dubbed given the multiple occasions she released violent criminals with little to no jail time despite guilty verdicts. Even the “Ragin’ Cajun” James Carville has weighed in on this race. He recently advised Ari Melber on MSNBC that progressives would do well to back off indicting Trump until after the April 4 election in Wisconsin, which he said is “for all the marbles.” Otherwise, such an indictment might drive too many Republicans and conservatives to the polls.
The Left has become a well-funded, fully manned machine designed to systematically deconstruct all that makes this Republic great. Recognizing this reality might be debilitating to many, but it shouldn’t be. And we cannot afford to let it.
Many think conservatives need to build a similar machine. In the long-term that might be the case. In the short term, between now and election day, we have a powerful weapon to turn back these assaults on our constitutional way of life: voting.
But no one can sit on the sidelines. All must give of their time, talent and treasure. Every legal voter in Wisconsin must be sure they, and everyone they know, votes on April 4 for Daniel Kelly. To those who can donate: please do so at www.JusticeDanielKelly.com—no matter where you live in the United States. And give of your time and talents in this race or in your local elections.
If the Soros-led assault on the Wisconsin Supreme Court can be successfully thwarted, it will be a first and defining victory against the newest front the progressive Left has opened in its war against the United States.
If conservatives fail to hold the line in Wisconsin, they can expect to see this latest political science experiment exported to other state Supreme Court races.
On this Carville is right: This is for all the marbles. Rather than cursing the darkness, be the light that dispels it by voting on April 4. Be the difference and live life boldly!
This article was written by a friend of Mammoth Nation, Joe Giganti. Joe is the host of The Regular Joe Show, a nationally syndicated daily radio show that originates from Green Bay, Wis. Learn more at: www.RegJoeShow.com
SAVE 30% on Mammoth Nation Memberships. Use promo code: REGULARJOE
-Mammoth Nation
Have you read these other posts?
DIRECTV brought back Newsmax - another victory for conservatives!
Are you prepared for a full recession? Our vendor Patriot Gold can help you today.
JOIN MAMMOTH
Shop your values and save!
Categories
Archives
- June 2024 (5)
- May 2024 (8)
- April 2024 (6)
- March 2024 (8)
- February 2024 (10)
- January 2024 (8)
- December 2023 (7)
- November 2023 (9)
- October 2023 (7)
- September 2023 (6)
- August 2023 (11)
- July 2023 (9)
- June 2023 (8)
- May 2023 (7)
- April 2023 (5)
- March 2023 (8)
- February 2023 (5)
- January 2023 (5)
- December 2022 (7)
- November 2022 (8)
- October 2022 (3)